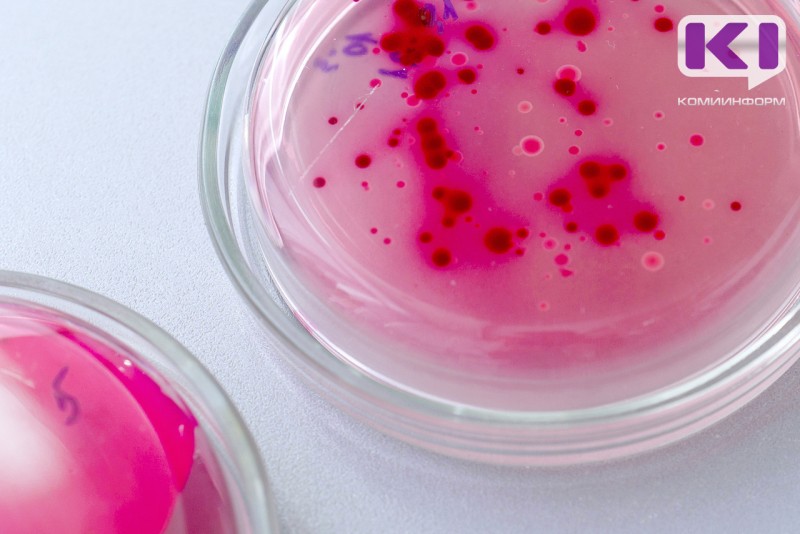
В Коми стали меньше болеть энтеровирусом, туберкулезом и педикулезом

В январе 2025 года в Республике Коми было зарегистрировано 27 573 случая инфекционных и паразитарных заболеваний. Это на 29,4% меньше, чем в январе 2024 года. Основное снижение произошло за счет уменьшения числа случаев гриппа, ОРВИ и COVID-19. Уровень заболеваемости оказался на 27,8% ниже среднего за много лет, сообщает Роспотребнадзор Коми.
За этот месяц не было зарегистрировано случаев таких заболеваний, как брюшной тиф, бактериальная дизентерия, острые гепатиты А и С, коклюш, корь, эпидемический паротит, менингококковая инфекция, дифтерия, псевдотуберкулез, туляремия, лептоспироз, листериоз, малярия и трихинеллез.
Заболеваемость паразитарными инфекциями снизилась на 30%, а острыми кишечными инфекциями, вызванными ротавирусами, — на 26,5%. Энтеровирусная инфекция, хронические вирусные гепатиты, скарлатина и микроспория остались на уровне января 2024 года. Количество случаев педикулеза сократилось в 2,4 раза.
Заболеваемость впервые выявленным туберкулезом снизилась на 13 случаев, включая туберкулез органов дыхания. Число больных бациллярными формами туберкулеза также уменьшилось на 8 случаев.
Однако был зафиксирован рост заболеваемости острыми кишечными инфекциями (ОКИ) на 92,5%. Это включает ОКИ установленной этиологии, которые увеличились на 82,2%, в том числе вызванные вирусами — на 80,5%, включая вирусы Норволк — в 3,4 раза. Также возросла заболеваемость ОКИ неустановленной этиологии — в 2 раза. Заболеваемость ветряной оспой увеличилась на 23,6%, а внебольничной пневмонией — на 3,4%.
Ситуация находится под постоянным контролем Управления Роспотребнадзора по Республике Коми.